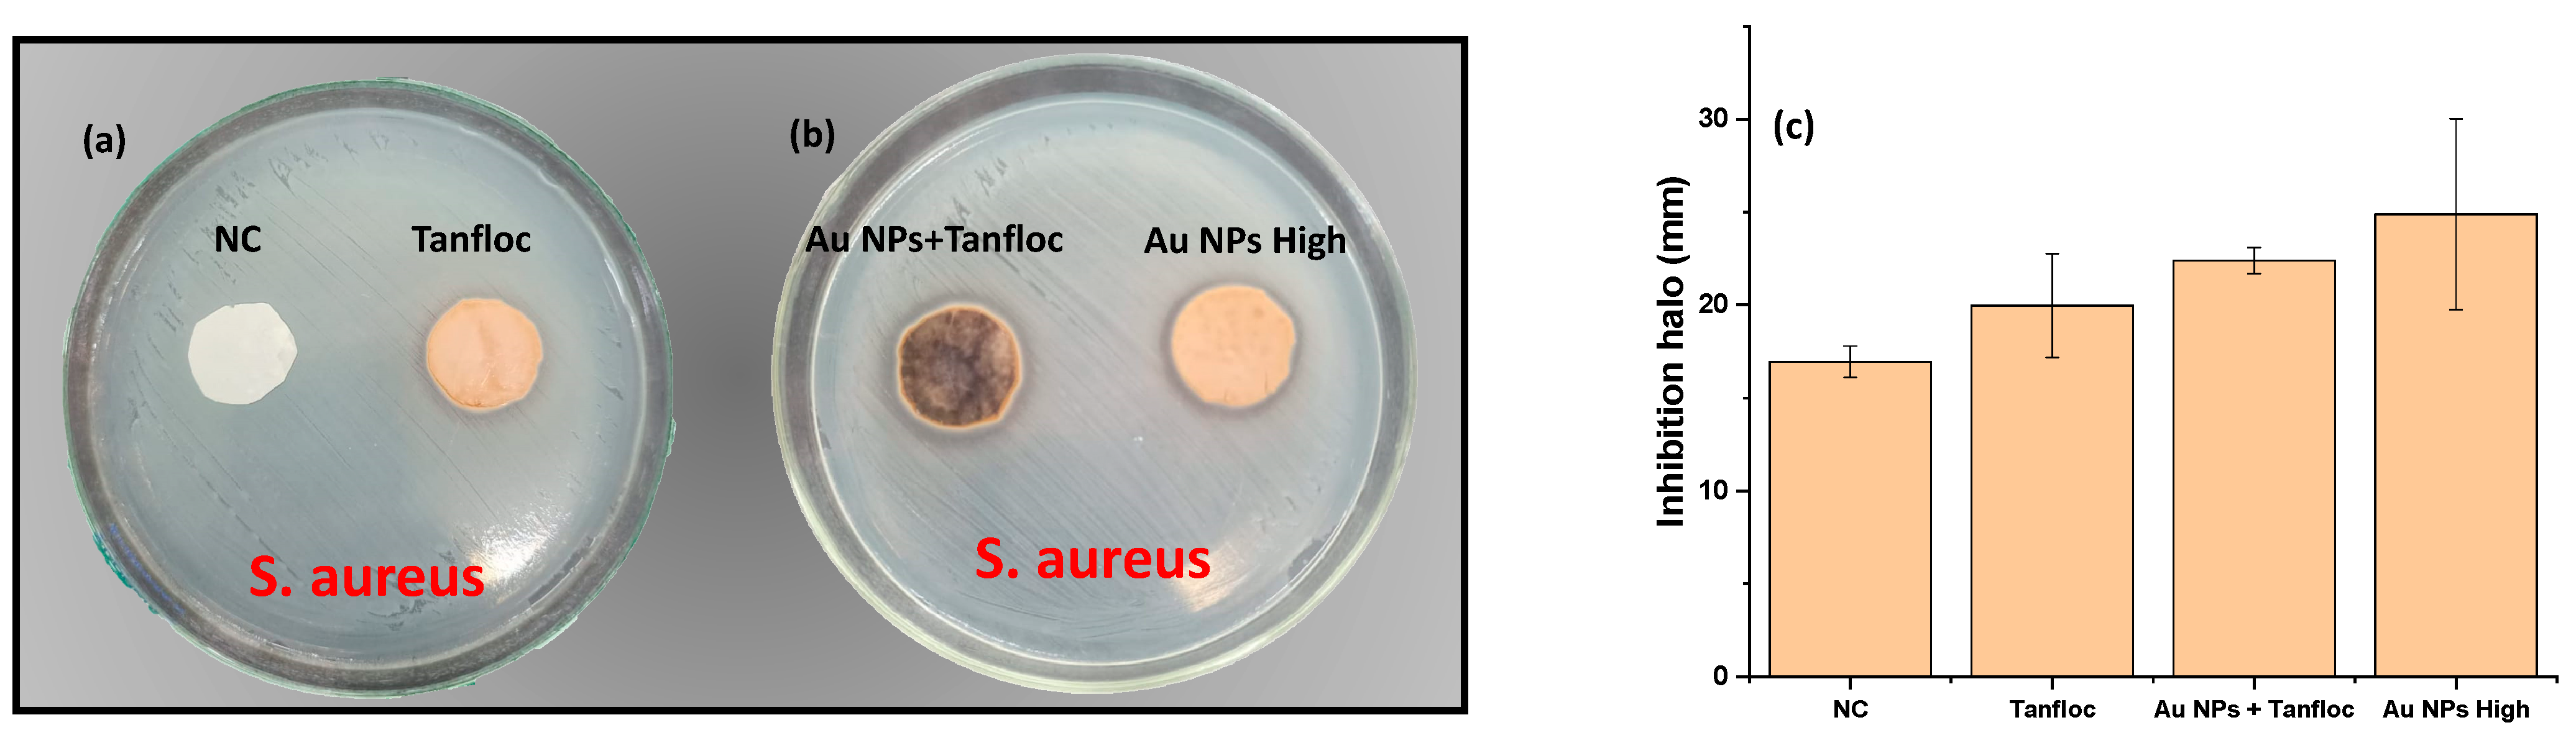
Biochem 02 00019 g005

1. Introduction
The bio-assisted synthesis of metal nanoparticles (gold and silver nanoparticles) appears as an eco-friendly procedure in which plant-derived compounds (such as polyphenolic groups) [
1] associate reducing properties to antioxidant and several beneficial properties such as the antimicrobial and anti-inflammatory activity of the natural components. It avoids the use of harsh reagents (such as tri-sodium citrate, sodium borohydride, hydrazine and lithium tri(ethyl)borohydride) [
2,
3] that takes place to the concept of “from nature to nature”, exploring the use of plant extracts and derivatives as promising multifunctional templates for the development of new materials [
4] with applications in the Internet of Things [
5], wearables [
6], agriculture [
7] and health [
8,
9,
10], sensors and catalysis [
3,
11,
12,
13,
14].
The general mechanism attributed to the antibacterial activity of gold nanoparticles is their ability to permeate into the bacterial cell barrier, destroying the structure and provoking damage to the bacteria [
15]. The surface charge of gold nanoparticles (Au NPs) is an important parameter to be considered in the overall antibacterial activity of the material since aggregation reduces the active surface area of the material [
16]. In addition, cationic Au NPs have been considered promising candidates against several multidrug-resistant bacteria due to the combined electrostatic properties of the surface charge of nanoparticles and negatively charged bacteria [
17]. The generation of reactive oxygen species (ROS) for these nanoparticles causes protein denaturation, DNA damage, and cell death [
15].
The antibacterial activity of metal nanoparticles can be synergistically associated with the intrinsic properties of the reducing agents (eco-friendly and multifunctional materials) to circumvent the selection of antibiotic-resistant organisms. In particular, tannins are polyphenol-based structures composed of a central glucose unit surrounded by gallic acid molecules characterized as environmentally friendly compounds applied in health solutions [
4,
18,
19,
20,
21]. The metal reduction process based on tannin-derived compounds is established under redox reactions, from the conversion of phenolic groups into quinones by donating electrons to reduce Au
3+ into Au
0, [
2,
16,
18,
22] with advantages of a reaction conducted at ambient temperature [
23].
The development of coagulants from tannin extracts represents another important strategy to provide remediation in residual water. Based on this property, polymeric coagulants produced from tannin extracts have been progressively reported in the literature, such as a cationic compound (Tanfloc
®) produced from tannin extract of
Acacia mearnsii—considered as a condensed-type tannin. The procedure for the conversion is based on the Mannich method, which relies on the incorporation of the imine cation -CH
2NH
3+ that provides the cationic behavior to the modified polymeric structure. The resulting material (Tanfloc
®) is produced by Tanac S.A. (Brazil), and the structure of the material is shown in [
24].
The most common application for Tanfloc has been considered in the destabilization of contaminants in wastewater, provoking the neutralization of compounds and the formation of micro flakes. An interesting aspect to be considered is that the interaction between Tanfloc and the bacterial cell wall is reinforced by the prevailing electrostatic interaction of the cationic behavior of Tanfloc and the negative charge of the bacteria with direct consequences on the inhibition of bacterial growth in aqueous solution—the corresponding experimental for a synthetic system has been explored by our group from the interaction of positively charged chains of polypyrrole and bacteria as strong antibacterial agents [
9,
10,
25]. The biomedical application of conventional gold nanoparticles has been considered in an increasing number of papers that have been focused on applications involving sensing, drug delivery, imaging and photodynamic therapy-based assays [
26,
27,
28,
29]. Relative to the Tanfloc, explored as an antioxidant and reducing agent, it is important to cite relevant papers in areas that consider this polymer as a biomaterial, with reported minimal toxicity against mammalian cells [
30] and relevant application as a polyelectrolyte complex for biomedical applications in which good results are observed in terms of the stem cells adhesion and proliferation [
31].
Herein, the activity of Tanfloc applied to the reduction of gold metal nanoparticles is associated with the electrostatic response of the cationic polymer and synthesized nanoparticles as strong antibacterial agents against Staphylococcus aureus. The evaluation of this response was performed in terms of the antibiofilm activity, kill-time assays and inhibition haloes. The results confirmed the combined action of reduced gold nanoparticles with Tanfloc and the relevance of the cationic polymer in the solution applied in the improvement of the overall antibacterial activity of the material.
2. Materials and Methods
2.1. Materials
Tryptic soy broth (TSB) was acquired from Fluka (Atlanta, GA, USA), Mueller–Hinton Agar from Himedia (Sumaré, SP, Brazil), and phosphate-buffered saline (PBS), plate counter agar (PCA) and chloroauric acid were acquired from Aldrich (Saint Louis, MO, USA). Cationic Tanfloc was donated by TANAC S.A., (Montenegro, RS, Brazil), and all of the compounds were used as received. Ethyl alcohol and acetone (Vetec, Duque de Caxias, RJ, Brazil) and Milli-Q water were used in the preparation of the solutions.
2.2. Methods
The structure of the Tanfloc was scrutinized by Fourier transform infrared assays, using the KBr method in a Shimadzu Fourier transform infrared spectrometer IR Prestige-21 (Shimadzu, Kyoto, Japan). Surface morphology and Energy Dispersive X-Ray Analysis (EDX analysis) were recorded by a Scanning Electron Microscope SEM 3 TESCAN. The nanoparticle size was determined in a Malvern Nano-ZS90 zeta sizer (Malvern Panalytical, Malvern, UK). The absorption spectra in the ultraviolet-visible region of the gold nanoparticles were measured by a Hach DR500 UV-vis spectrometer (Hach, Loveland, CO, USA) in the range of 300–800 nm.
2.3. Synthesis of Gold Nanoparticles
Before the synthesis of gold nanoparticles, two important assays were conducted: the optimization in the concentration of the reducing agent (Tanfloc) to reach the adequate reduction of gold nanoparticles in the solution and the determination of the minimum bactericidal concentration (MBC) of Tanfloc in water. These results were combined to provide the optimal combined condition for the reduction of gold nanoparticles and antibacterial activity against Staphylococcus aureus (ATCC 25923), by the association of the intrinsic properties of gold nanoparticles with the antibacterial properties of the cationic polymer net. Based on these preliminary assays, two-level values for the concentration of Tanfloc were defined: the low concentration (C0 = 0.5 mg/mL) of Tanfloc represents the best condition for the production of gold nanoparticles and a high concentration (C1 = 0.2 g/mL) of Tanfloc that introduces the intrinsic antibacterial activity of cationic polymer against S. aureus (above the Minimum Bactericidal Concentration—MBC).
To combine these effects, two different levels of concentration of Tanfloc (C
0 and C
1) were explored in the preparation of three different experimental systems: the low concentration of Tanfloc (C
0) was applied in the synthesis of gold nanoparticles, as described in
Section 2.3.1 (defined as Au NPs system); a second experiment approach in which the Au NPs system (prepared at concentration C
0) received an aliquot of Tanfloc to reach a concentration above the MBC level (C
1), described in
Section 2.3.2 as Au NPs + Tanfloc system and a sample prepared with the solution of Tanfloc above the MBC (C
1) applied in the production of gold nanoparticles (as described in
Section 2.3.3 with the experimental system defined as Au NPs High).
2.3.1. Synthesis of Gold Nanoparticles (Low Concentration of Tanfloc)—Au NPs
An aqueous solution of gold metal salt (HAuCl4—0.01 M) in 100 mL—solution #1—was prepared and kept at ambient temperature. A second aqueous solution (200 mL) containing C0 = 0.5 mg/mL of Tanfloc (green reducing agent)—solution #2 was also prepared and stored at the dark condition and ambient temperature. Then, an aliquot of 3 mL from solution #1 was slowly dropwise into 47 mL of solution #2 under intense stirring for 3 min at ambient temperature. Under reaction, the solution acquires a red wine color in an indication that the reduction process takes place and metal nanoparticles are produced.
2.3.2. Preparation of Gold Nanoparticle Supplemented by Tanfloc to Reach MBC Concentration (Au NPs + Tanfloc)
The same procedure for the preparation of gold nanoparticles reported in
Section 2.3.1 was conducted. After that, to acquire the antibacterial activity of the Tanfloc, an extra amount of 19.95 g of Tanfloc was incorporated in 100 mL of green gold nanoparticles (Au NPs + Tanfloc system).
2.3.3. Synthesis of Gold Nanoparticles at a High Concentration of Tanfloc (Au NPs High)
An alternative to synthesize gold nanoparticles associated with the intrinsic antibacterial activity of Tanfloc was provided from the direct reduction of gold nanoparticles at a high concentration of Tanfloc in an aqueous solution. For this, 3 mL of solution #1 (as defined in
Section 2.3.1) was slowly added dropwise into 100 mL of an aqueous solution of Tanfloc prepared at a concentration of C
1 = 0.2 g/mL (system Au NPs High).
2.4. Antibacterial Assays
2.4.1. Determination of the Minimum Bactericidal Concentration (MBC)
The evaluation of the MBC for the three different systems (Au NPs, Au NPs + Tanfloc and Au NPs High) was performed against
S. aureus following a standard procedure reported in [
10] that is based on the successive micro dilutions of antibacterial agents. As a first step, 100 μL of Muller–Hinton liquid medium was distributed in each well of the microplates. Then, an aliquot of 100 μL of each sample under analysis (Au NPs, pure Tanfloc (Tan), Au NPs + Tanfloc, and Au NPs High) was added to the first column of the microplate. After the homogeneous dispersion of antibacterial agents, aliquots of 100 μL were transferred to the sequence successively until the complete plate in a continuous serial dilution that follows the reduction of the initial concentration by ½: (1:1; 1:2; 1:4; 1:8; 1:16; 1:32; 1:64; 1:128) relative to the initial concentration of the antibacterial agent. In the following step, the inoculum preparation was conducted, in which 5 mL of the saline solution received a bacterial suspension of 10
8 CFU/mL, calculated by the intensity of the characteristic absorption peak of bacteria in the UV-vis spectrum (centered at 580 nm). From this suspension, 100 μL of bacterial culture was transferred to a tube containing 9.9 mL of Muller–Hinton liquid medium from which aliquots of 10 μL were transferred to each well of the microplate. The solutions in the microplate were incubated at 37 °C for 24 h. After that, using a multichannel replicator, the content of microplate wells was inoculated in plates containing Muller–Hinton Agar (MHA) that were kept at 37 °C for 24 h to allow the growth of bacterial species under treatment. Based on this method, the MBC was calculated as the lowest concentration of the antibacterial agent that provokes the death of the bacteria.
2.4.2. Agar Diffusion Assays
The agar diffusion assays were conducted according to methods described in [
32]. The bacterial inoculum of Gram-positive bacteria (
S. aureus) was prepared from a bacterial culture kept in agar at 4 °C. After the preparation of a saline solution with bacteria at 10
8 CFU/mL, the resulting material was dispersed in Petri dishes containing MHA. After this step, the material to be tested (incorporated into disks of eggshell membranes) was deposited on bacterial culture and inoculated at 37 °C for 24 h. The bacterial inhibition in the form of inhibition haloes was evaluated by direct visual inspection.
2.4.3. Kill-Time Assays
The determination of the kinetics of the bacterial inhibition of AuNPs and Tanfloc in solution was evaluated as follows: reactors containing 5 mL of bacterial solution at 108 CFU/mL received different antibacterial agents to reach the desired concentration of 2 × MBC (that corresponds to 700 μL of Tanfloc solution, Au NPs + Tan and Au NPs High from the mother solution). As the following step, aliquots of 100 μL of bacterial solution containing the antibacterial agent (at 2 × MBC and treated for a fixed interval of time—30 min, 60 min, 90 min, 120 min and 150 min) were removed from the reactor and inoculated in a Petri dish with plate counter agar (PCA) and kept at 37 °C for 24 h. After this step, the direct counting of viable cells in the plate was evaluated, determining the remaining viable cell colonies as a function of interaction time with the antibacterial agent. The information provided by antibiofilm, inhibition halo and kill-time assays can be explored not only to provide information about bacterial inhibition effectiveness, but also the kinetics of the antibacterial activity.
2.4.4. Biofilm Formation
Inocula of S. aureus were dispersed in 10 mL of tryptic soy broth (TSC) media in different tubes. Then, 5 mL of antibacterial solutions (Tanfloc, Au NPs + Tanfloc and Au NPs High) in addition to a tube containing the negative control (no antibacterial agent) were prepared in the presence of bacteria. The solutions were kept at 37 °C for 24 h. After this step, the quantification of the relative formation of biofilm was evaluated as follows: after the removal of the bacterial solution in all of the tubes, the procedure of washing with water was conducted. Then, a solution of crystal violet (1%) was added to the tube and remained in contact with the biofilm for 3 min to stain the adhered structures. The dye solution was removed and the tube was washed with water. The removal of the marked biofilm was evaluated under washing with a solution of alcohol/ acetone 80:20 with the relative amount of marked biofilm cells determined comparatively from the intensity of the absorbance of the negative control (absence of the antibacterial agent) in the UV-vis region.
3. Results and Discussion
The structure of Tanfloc was scrutinized by the FTIR spectrum shown in
Figure 1a, in which it is possible to identify peaks and bands in the measured absorbance of the samples. The broad band in the range of 3100–3600 cm
−1 (centered at 3389 cm
−1) is assigned to the stretching frequencies of the O-H and N-H groups. The shoulder at 2477 cm
−1 is part of a band of amine groups [
33], aromatic compounds at 1611 cm
−1 [
34], absorption band attributed to the -CH
3 at 1463 cm
−1 and band at 1135 cm
−1 assigned to the C-O stretching vibration in the compound. A possible mechanism for the gold nanoparticle reduction by the action of the Tanfloc is summarized in
Figure 1b. It is a two-step process in which the adsorption of HAuCl
4 is followed by the reduction of gold nanoparticles on Tanfloc. As reported in the literature [
31], Tanfloc is an amino-functionalized tannin-derivative with intrinsic properties of a polycation compound at diluted acidic aqueous media. As a consequence, the uptake of Au (III) species takes place under the electrostatic interaction of gold salt and amine groups on Tanfloc with the following step of redox reaction in which three electrons are lost to reduce species to Au (0) from the conversion of phenolic hydroxyl groups (abundant in the structure of Tanfloc) into carbonyl groups, as schematically drawn in
Figure 1b.
3.1. Characterization of “Green” Gold Nanoparticles
The distribution of aggregates of Tanfloc and gold nanoparticles in the Au NPs system was evaluated from SEM images with the identification of Au nanoparticles by EDS overlaid images (as shown in
Figure 2a,b). As can be seen, aggregates of Tanfloc are identified in
Figure 2a with a diameter in the order of hundreds of nanometers characterizing small domains of Tanfloc (
Figure 2a) in which gold nanoparticles are homogeneously dispersed. Due to the nanoscale size of these nanoparticles, the observation of gold is only possible by the EDX overlaid images (shown in
Figure 2b) in which gold elements are identified by red dots.
The distribution of the hydrodynamic diameter of synthesized gold nanoparticles was evaluated by dynamic light scattering assays, as shown in
Figure 3a. The measured distribution of Au NPs was characterized by a dual size distribution centered at 2.7 nm and 68.1 nm, while a single distribution of size is observed for system Au NPs + Tanfloc—with a peak centered at 458.7 nm, which is in agreement with the size of the aggregates observed from SEM images, in an indication that progressive coating of gold nanoparticles by Tanfloc aggregates is established under the increasing concentration of the polymer in the solution of synthesized gold nanoparticles. As for the Au NPs High, it presented a dual size distribution of hydrodynamic diameters centered at 91.28 nm and 531.2 nm in correspondence with that observed for the Au NPS system, with the increase in the size of nanoparticles confirming that a coating layer of Tanfloc on gold nanoparticles is established at a high concentration of the tannin-derived compound. As observed, the high concentration of Tanfloc results in aggregates impregnated with gold nanoparticles.
Another important method to elucidate the adequate reduction of gold nanoparticles is established from the measurement of the plasmonic band of the metal nanoparticles, which are determined by the absorption spectrum in the visible region (400–800 nm). As shown in
Figure 3b, the characteristic peak at 524 nm corresponds to the plasmonic band of gold nanoparticles with a size in the order of 20 nm [
35]. The UV-vis spectrum for samples prepared at high concentrations (C
1) of Tanfloc is affected by the dispersion of a high amount of reducing agent, inhibiting the direct quantification of the plasmonic band of embedded gold nanoparticles. At high concentrations of the Tanfloc, the absorbance is reinforced in the UV region and the characteristic plasmonic band is changed to a slight shoulder, introducing additional difficulties for the determination of the characteristic size of the dispersed gold nanoparticles.
3.2. Antibacterial Assays
The MBC assays were performed against
S. aureus by evaluating the activity of Tanfloc, Au NPs High and Au NPs + Tanfloc (all of these samples with an initial concentration C
1 of Tanfloc of 0.2 g/mL) and Au NPs (prepared at an initial concentration C
0 of Tanfloc of 0.5 mg/mL) in addition to the corresponding positive and negative controls. As shown in
Figure 4, and as expected, all of the lines for the corresponding columns of positive and negative control returned the growth of bacteria (for positive control) and the absence of viable cells in the negative control (see
Figure 4a), characterizing the adequate growth of bacteria and the absence of contaminants in the media—control experiments.
As observed in the column for samples prepared at low concentration of Tanfloc (sample Au NPs—marked in yellow) the complete growth of bacteria in all ranges of concentration of Au NPs indicates that the isolated action of gold nanoparticles and a low concentration of Tanfloc is not sufficient to control the bacterial growth—the concentration of synthesized nanoparticles and Tanfloc is lower than the corresponding value for MBC of
S. aureus. On the other hand, as shown in the columns marked in blue for system Tanfloc, the MBC is observed at C
0/16 (12.5 mg/mL) against
S. aureus (
Figure 4a). These values justify the negligible antibacterial activity observed in the system Au NPs (prepared in a concentration of 0.5 mg/mL of Tanfloc) that is below the MBC for
S. aureus—characterizing the concentration of Tanfloc as a critical factor in the definition of the antibacterial activity of the compound.
In correspondence, the MBC values against
S. aureus for Au NPS High and Au NPs + Tanfloc were C
0/16 (12.5 mg/mL)—see
Figure 4b—confirming the hypothesis that the concentration of Tanfloc dominates in the determination of the MBC of the overall compound. Inhibition halo assays were performed against
S. aureus to identify the activity of compounds (in terms of their diffusive properties) in the inhibition of the bacteria. As shown in
Figure 5a,b, a discrete inhibition halo is observed for samples Au NPs + Tanfloc, Au NPs High, and Tanfloc, while the sample NC (negative control) returned negligible activity against bacteria. These results indicate that a slight diffusion of antibacterial species takes place under the impregnation of gold nanoparticles and Tanfloc on eggshell membranes. The values of the inhibition halo are summarized in
Figure 5b, indicating the best performance for compounds prepared with Tanfloc and gold nanoparticles.
In terms of the antibiofilm activity, good performance is observed for Tanfloc-based compounds. Results in
Figure 6a were obtained from the direct comparison of the absorbance level of removed biofilm from treated samples with negative control (absence of antibacterial compounds). As can be seen, a strong inhibition in the biofilm formation is observed for all of the compounds with a statistical equivalence for all of the tested compounds, indicating that a high concentration of the Tanfloc is the most important factor for the antibiofilm activity of the resulting material since negligible biofilm reduction is observed for sample Au NPs (lower content of Tanfloc), confirming the relevance of the Tanfloc on antibiofilm activity for this compound.
Although the results shown in
Figure 6a indicate minimal activity of gold nanoparticles against biofilm, the most relevant contribution of the Au NPs is revealed from the kinetics of bacterial elimination, described as follows.
Figure 6b summarizes the dependence of bacterial inhibition as a function of the time of actuation of compounds (calculated from the counting of viable cells under treatment with antibacterial agents). As expected, the negative control experiments confirmed that uncountable viable cells (represented by several viable cells >10,000) after 150 min of reaction, while the antibacterial activity of the compounds was observed in the Au NPs + Tan system, which reduces to zero the number of viable cells after 120 min of contact with the material. A more discrete reduction in the number of viable cells with the time of reaction is observed for samples Au NPs High which reduces the initial concentration to a value of 6 CFU/mL after 10 min and samples containing Tanfloc reduced the concentration of bacterial viable cells to 150 CFU/mL. Despite the aspect that the Au NPs system can be considered in the experiments below the minimal bactericidal concentration (justifying the negligible activity as a sole component against biofilm) the most important aspect to be considered is that its presence affects the kinetics of kill time, making the fast action of Tanfloc against
S. aureus possible.
Based on these results and the reports about the effective bactericidal activity of the electrostatic interaction of compounds and negatively charged cell walls of bacteria, it is possible to propose a typical mechanism in which the reduction of metal nanoparticles is established by the redox reaction of phenolic hydroxyl groups of Tanfloc into carbonyl groups that provide the stabilization of the reduced gold nanoparticles by a Tanfloc polymeric net. As a result of an electrostatic-guided interaction of Au NPs decorated polycation polymer and bacteria, the direct interaction with negatively charged bacteria takes place, improving the contact of loaded gold nanoparticles and the bacterial cell surface. As a result, it is expected that the induction of high stress on cell walls by the accumulation of both antibacterial agents (cationic polymer and Au NPs) suggests that Au NPs can penetrate the cell wall and reach the cytoplasm for the following step of the breakdown of the cell and the leakage of cytoplasm and genetic content of the material [
36,
37]. On the other hand, the effective antibacterial activity of Tanfloc is justified by the general antibacterial role incorporated by tannin derivatives and their intrinsic activity suggests the penetration of the compounds into the bacterial cell walls, provoking an interference in the metabolism and inhibiting the sugar and amino acid uptake [
4].